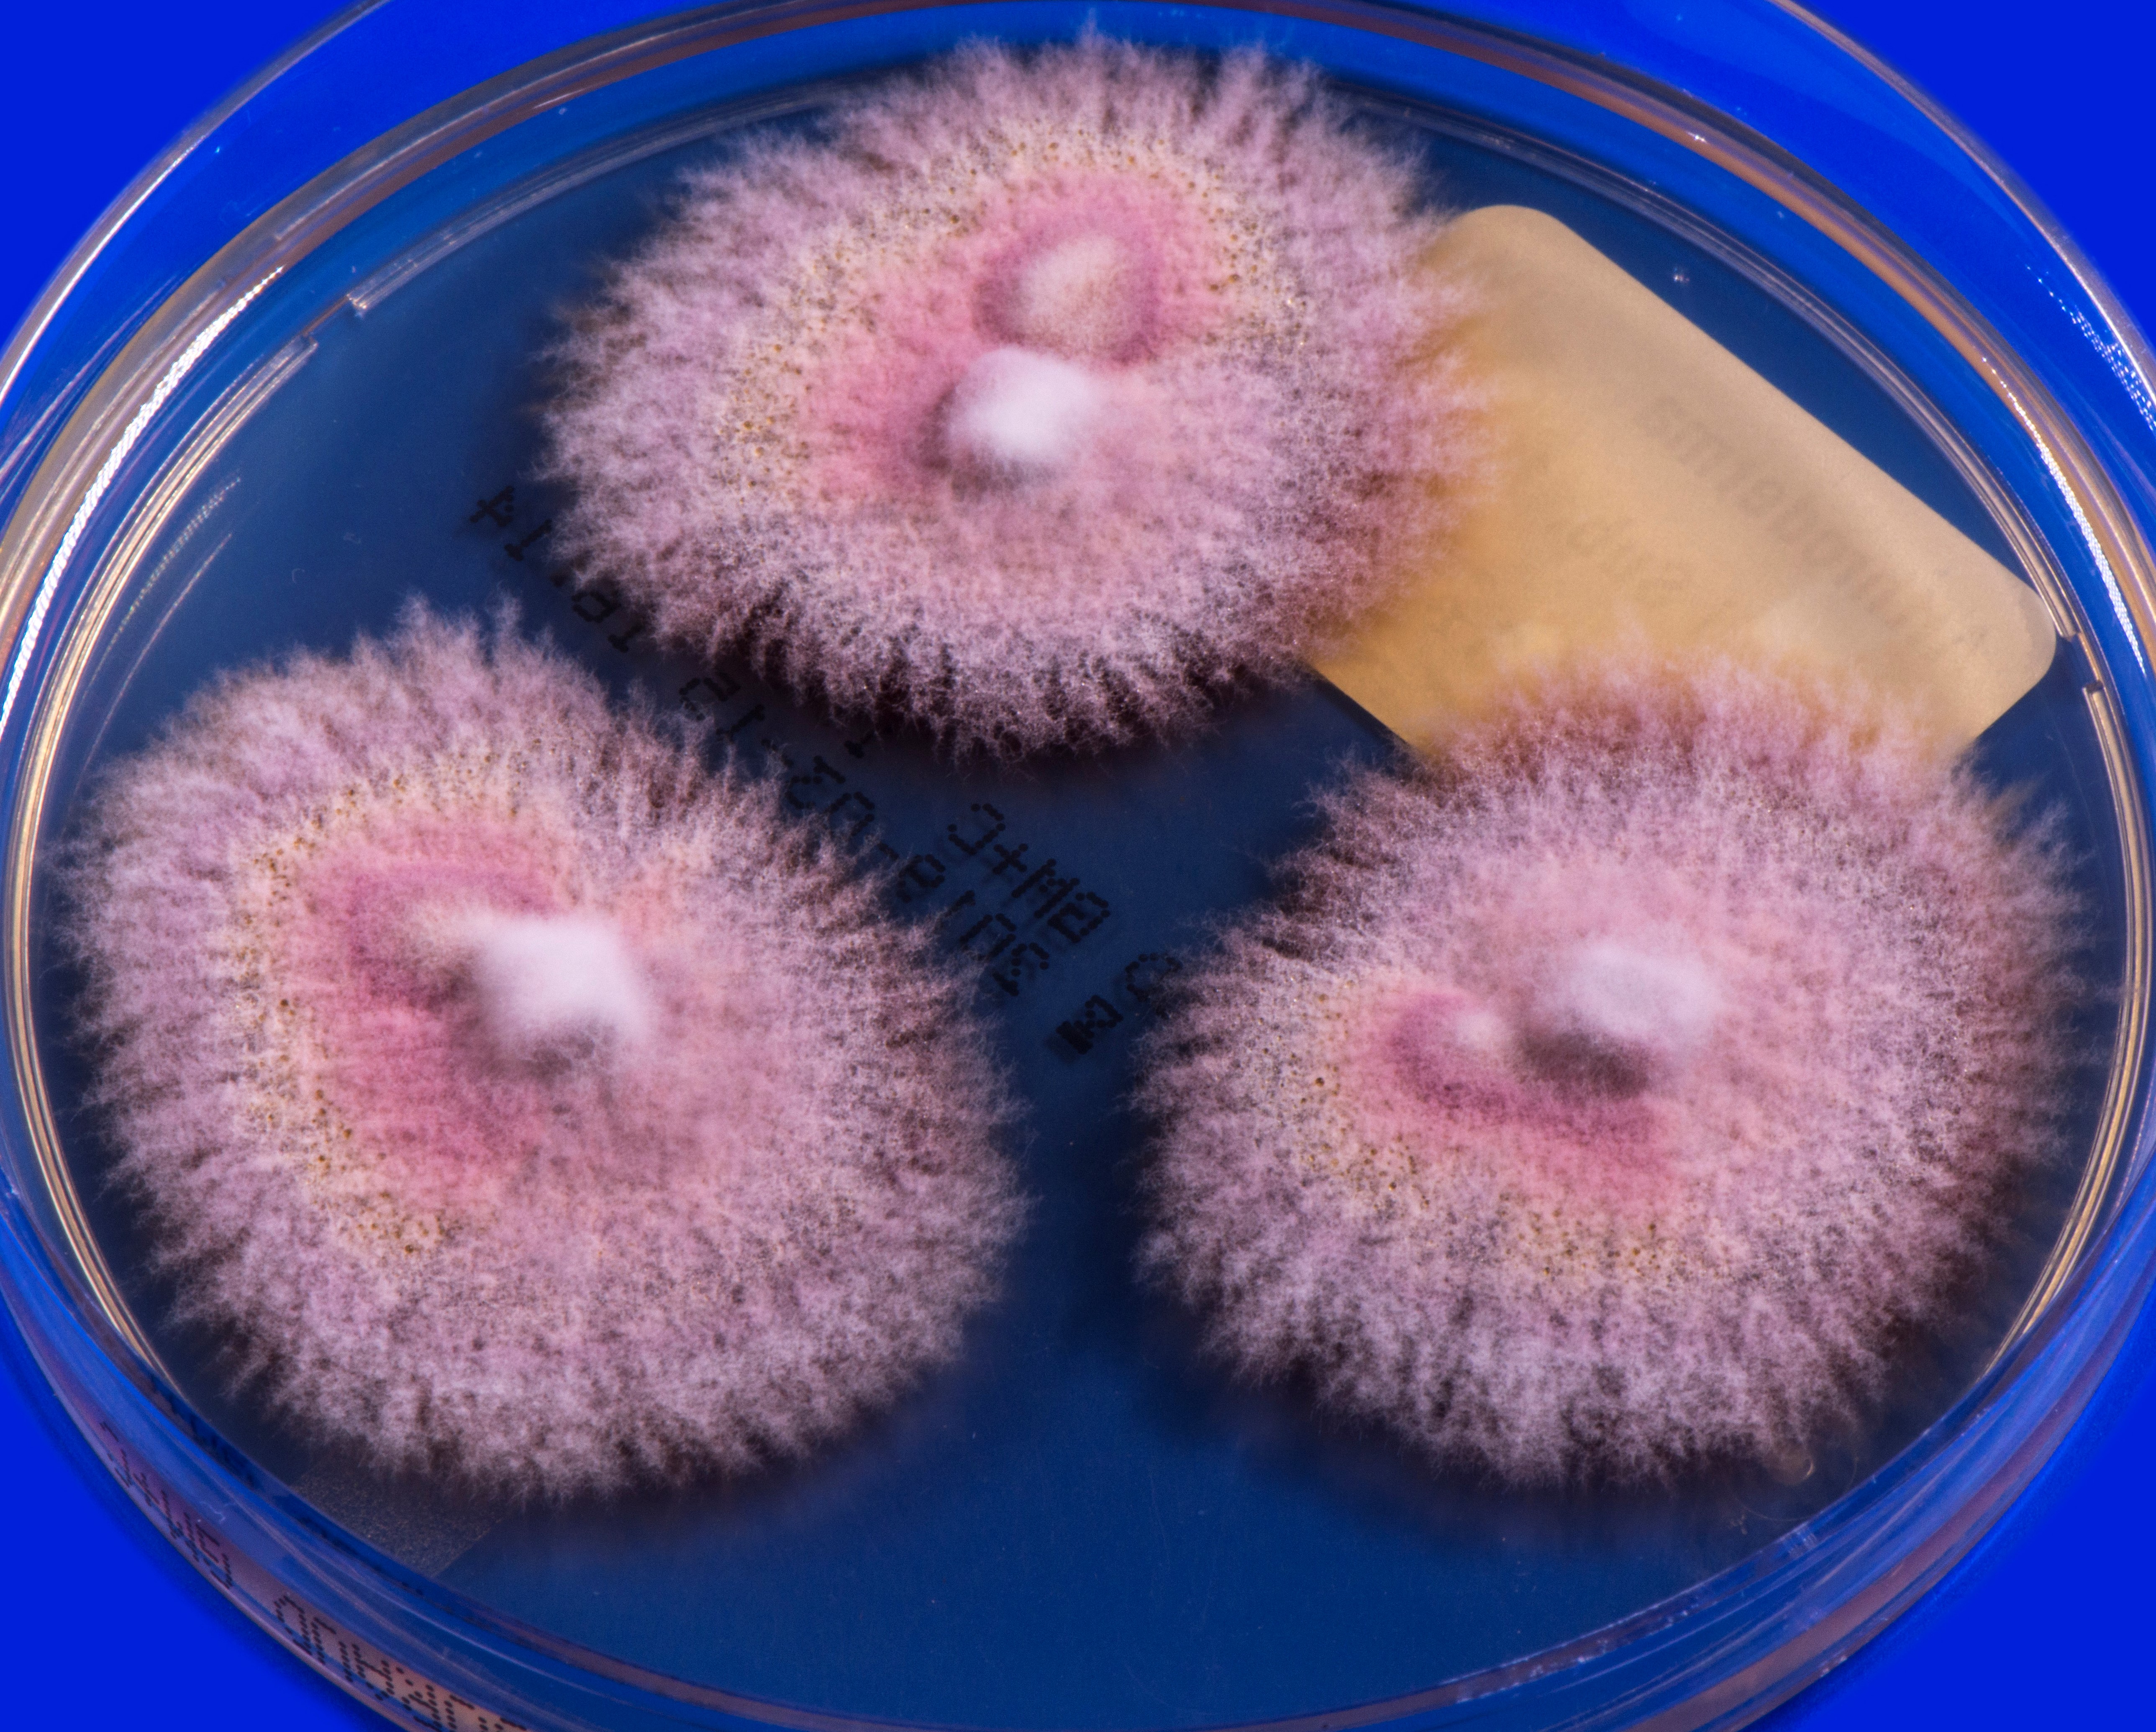
None
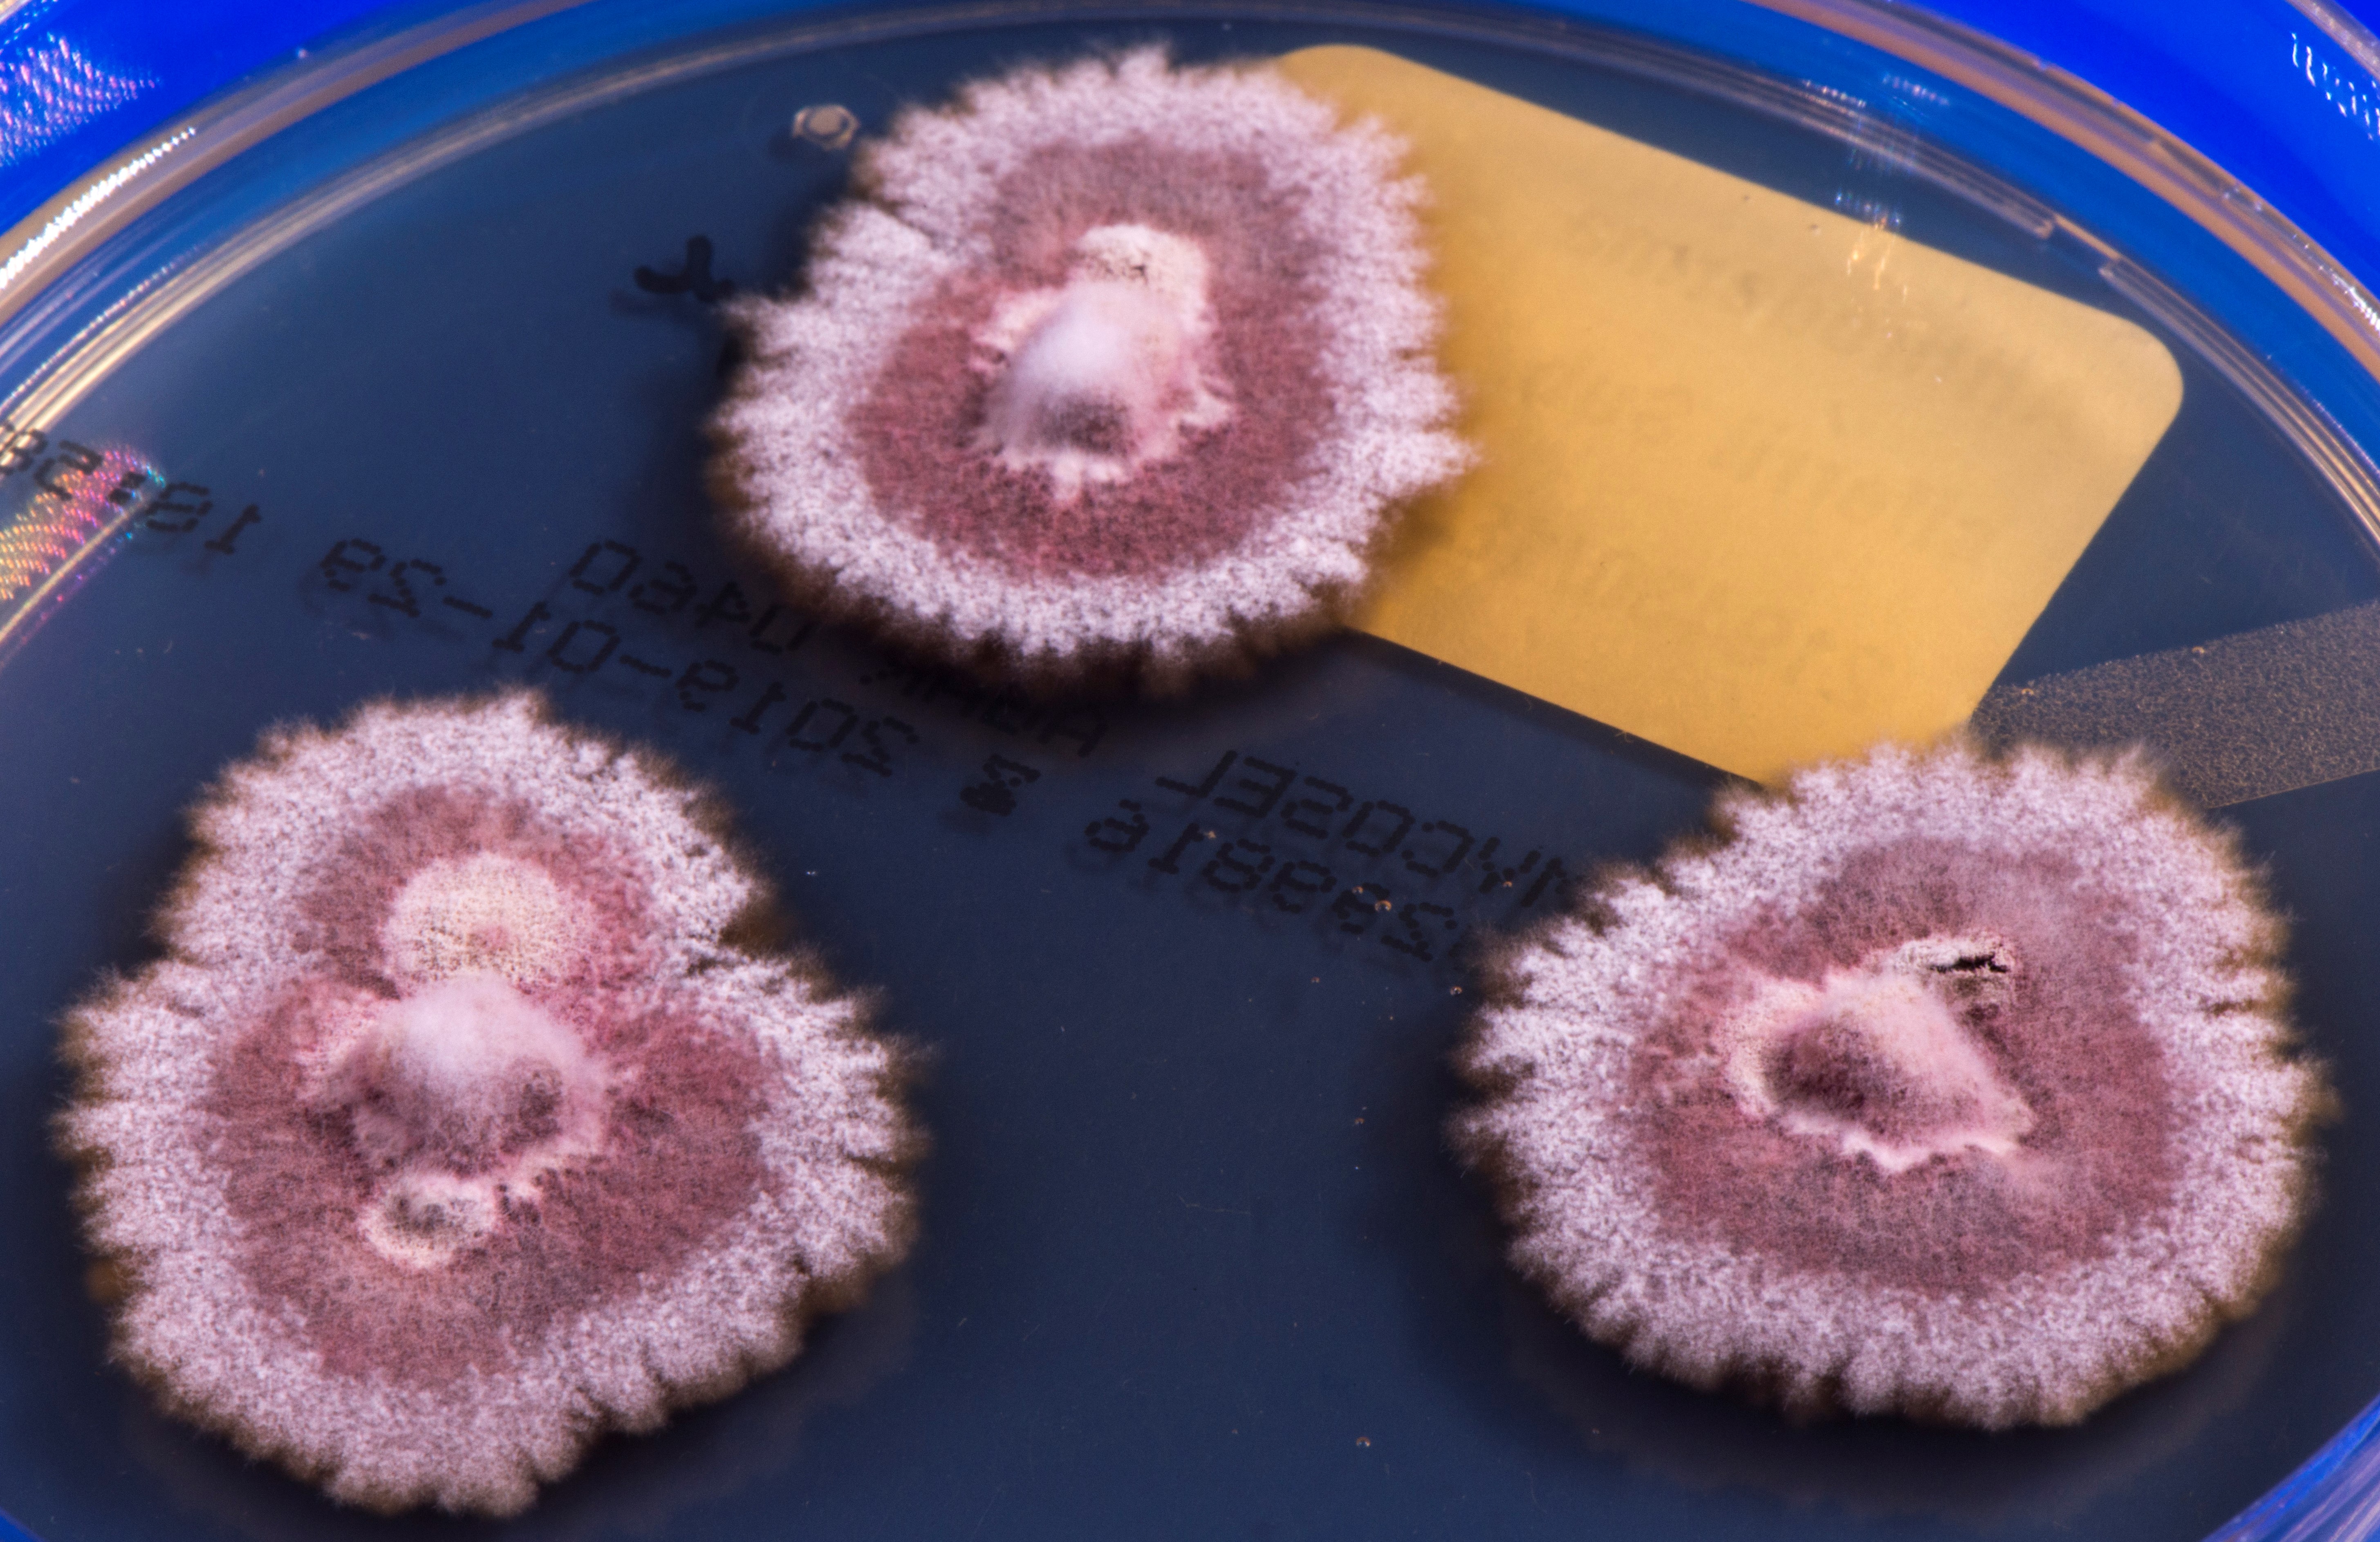
None
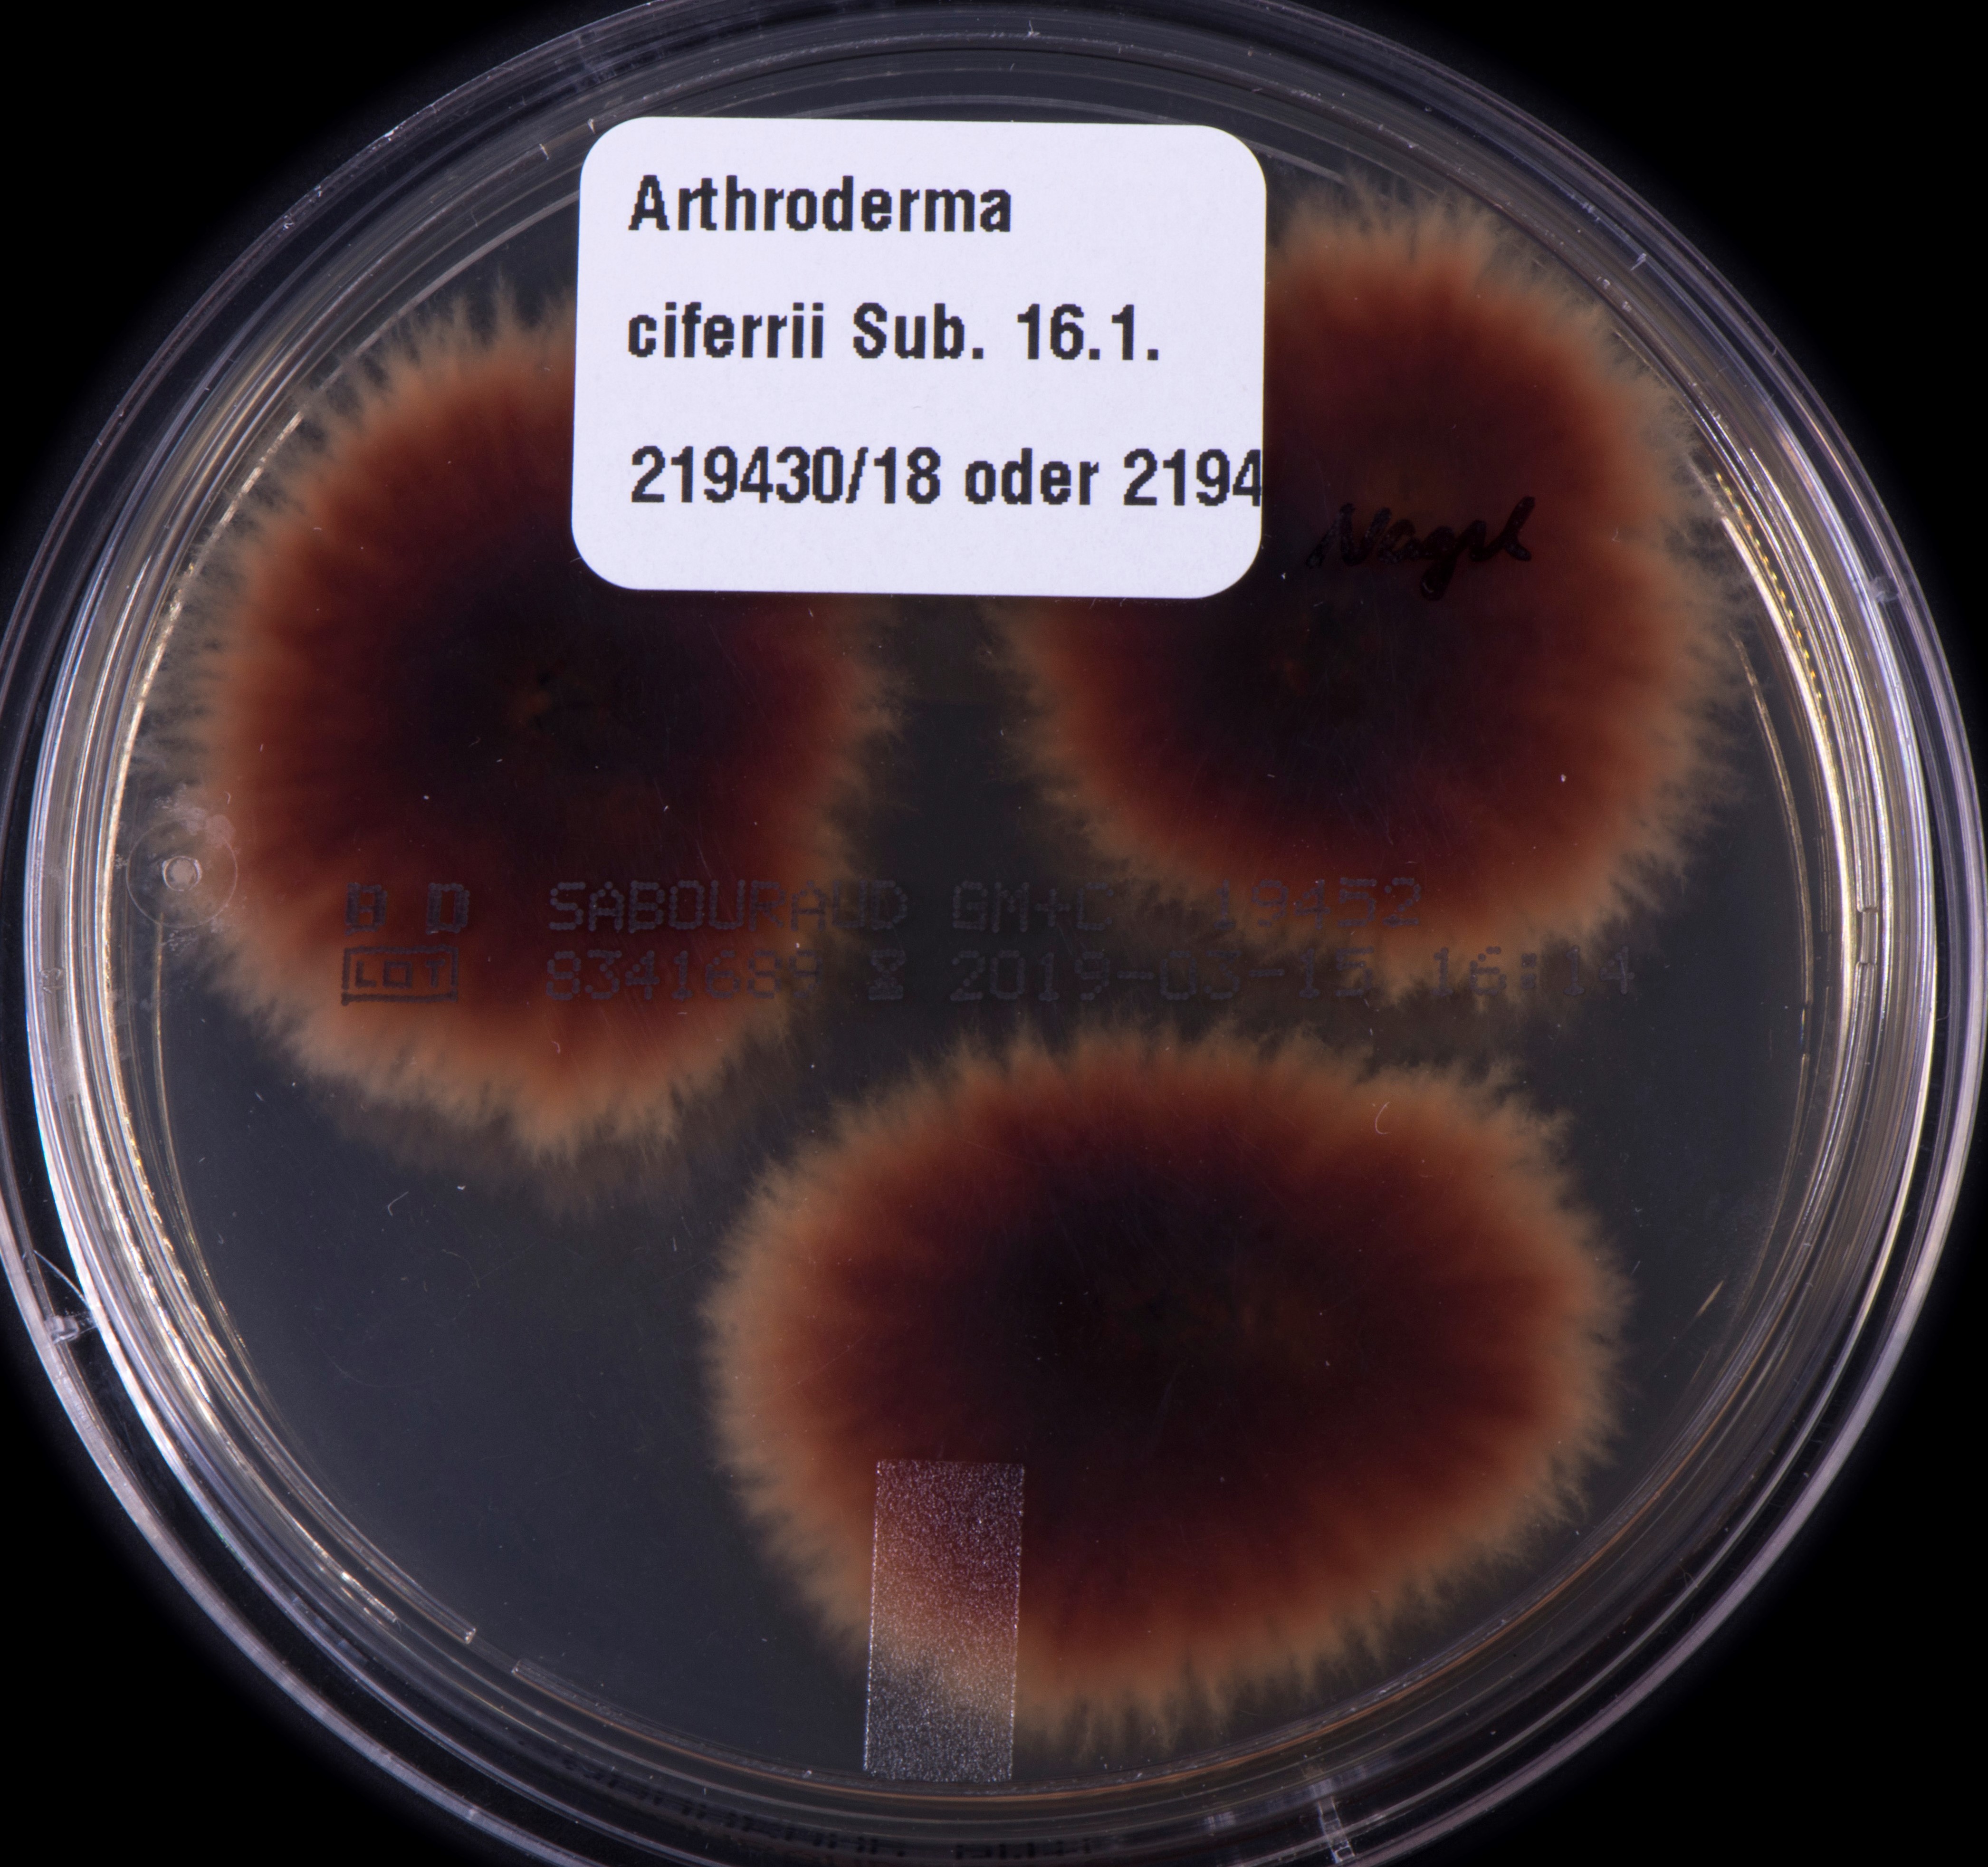
None

Arthroderma ciferrii Varsavsky & Ajello 1964
Arthroderma (A.) ciferrii (früher perfekte Form von Trichophyton georgiae Varsavsky & Ajello 1964, weiteres heterotypisches Synonym Chrysosporium georgiae Varsavsky & Ajello 1980) ist ein geophiler Dermatophyt, der weltweit im Erdboden und auch im Haar- und Federkleid wildlebender Tiere (Klein-Säugetiere und Vögel) nachgewiesen werden kann. A. ciferrii oder Chrysosporium georgiae fand sich auch in den Kämmen (Hahnenkämmen) von adulten Hühnern in diversen Hühnerställen in Hessen und Schleswig-Holstein in Deutschland. Bisher sind keine Infektionen durch A. ciferrii beschrieben worden, so dass beim Nachweis dieses Pilzes an eine Kontamination bzw. einen „Anflugkeim“ gedacht werden muss. Es besteht eine genetische Ähnlichkeit am ehesten zu A. onychocola (vorab Trichophyton onychocola), einem ebenfalls geophilen, erst kürzlich neu beschriebenem Dermatophyten. Darüber hinaus sind auch A. thuringiensis und A. melis eng verwandt mit A. ciferrii.